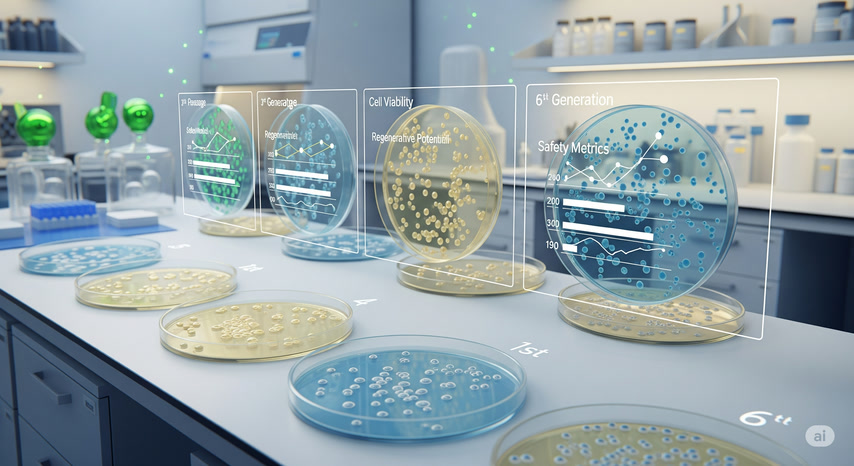
Lab Expansion and Generational Quality

Understanding Your
Stem Cell Source
The origin, handling, and certification of your stem cells directly impact both safety and treatment outcomes.

Source: Umbilical Cord-Derived Stem Cells
We use ethically sourced mesenchymal stem cells (MSCs) derived from donated umbilical cord tissue—specifically the Wharton’s Jelly—after full-term births. These are non-embryonic, non-invasive, and 100% voluntary donations made by healthy consenting mothers.
These cells offer high regenerative potential, strong anti-inflammatory properties, and low risk of immune rejection.
Lab Expansion and Generational Quality
To produce enough volume for therapeutic use, umbilical cord stem cells are expanded in controlled laboratory environments. To maintain quality and minimize biological risks, we exclusively use low-passage stem cells — typically between the 1st and 6th generation.
These early-passage cells retain optimal performance, viability, and regenerative potential, ensuring both safety and effectiveness in treatment.
How Our Process Differs
In many unregulated markets, clinics use over-expanded, poorly documented stem cells that may lack potency or even pose risk. In contrast, we guarantee:
Full traceability
Independent testing
Fresh, early-generation cells
GMP-standard handling
The Importance of Stem Cell Source
Your Health Deserves Verified Stem Cells
With rigorous sourcing, early-generation expansion, and certified safety testing, we deliver scientifically validated regenerative care you can trust.
GET STARTED